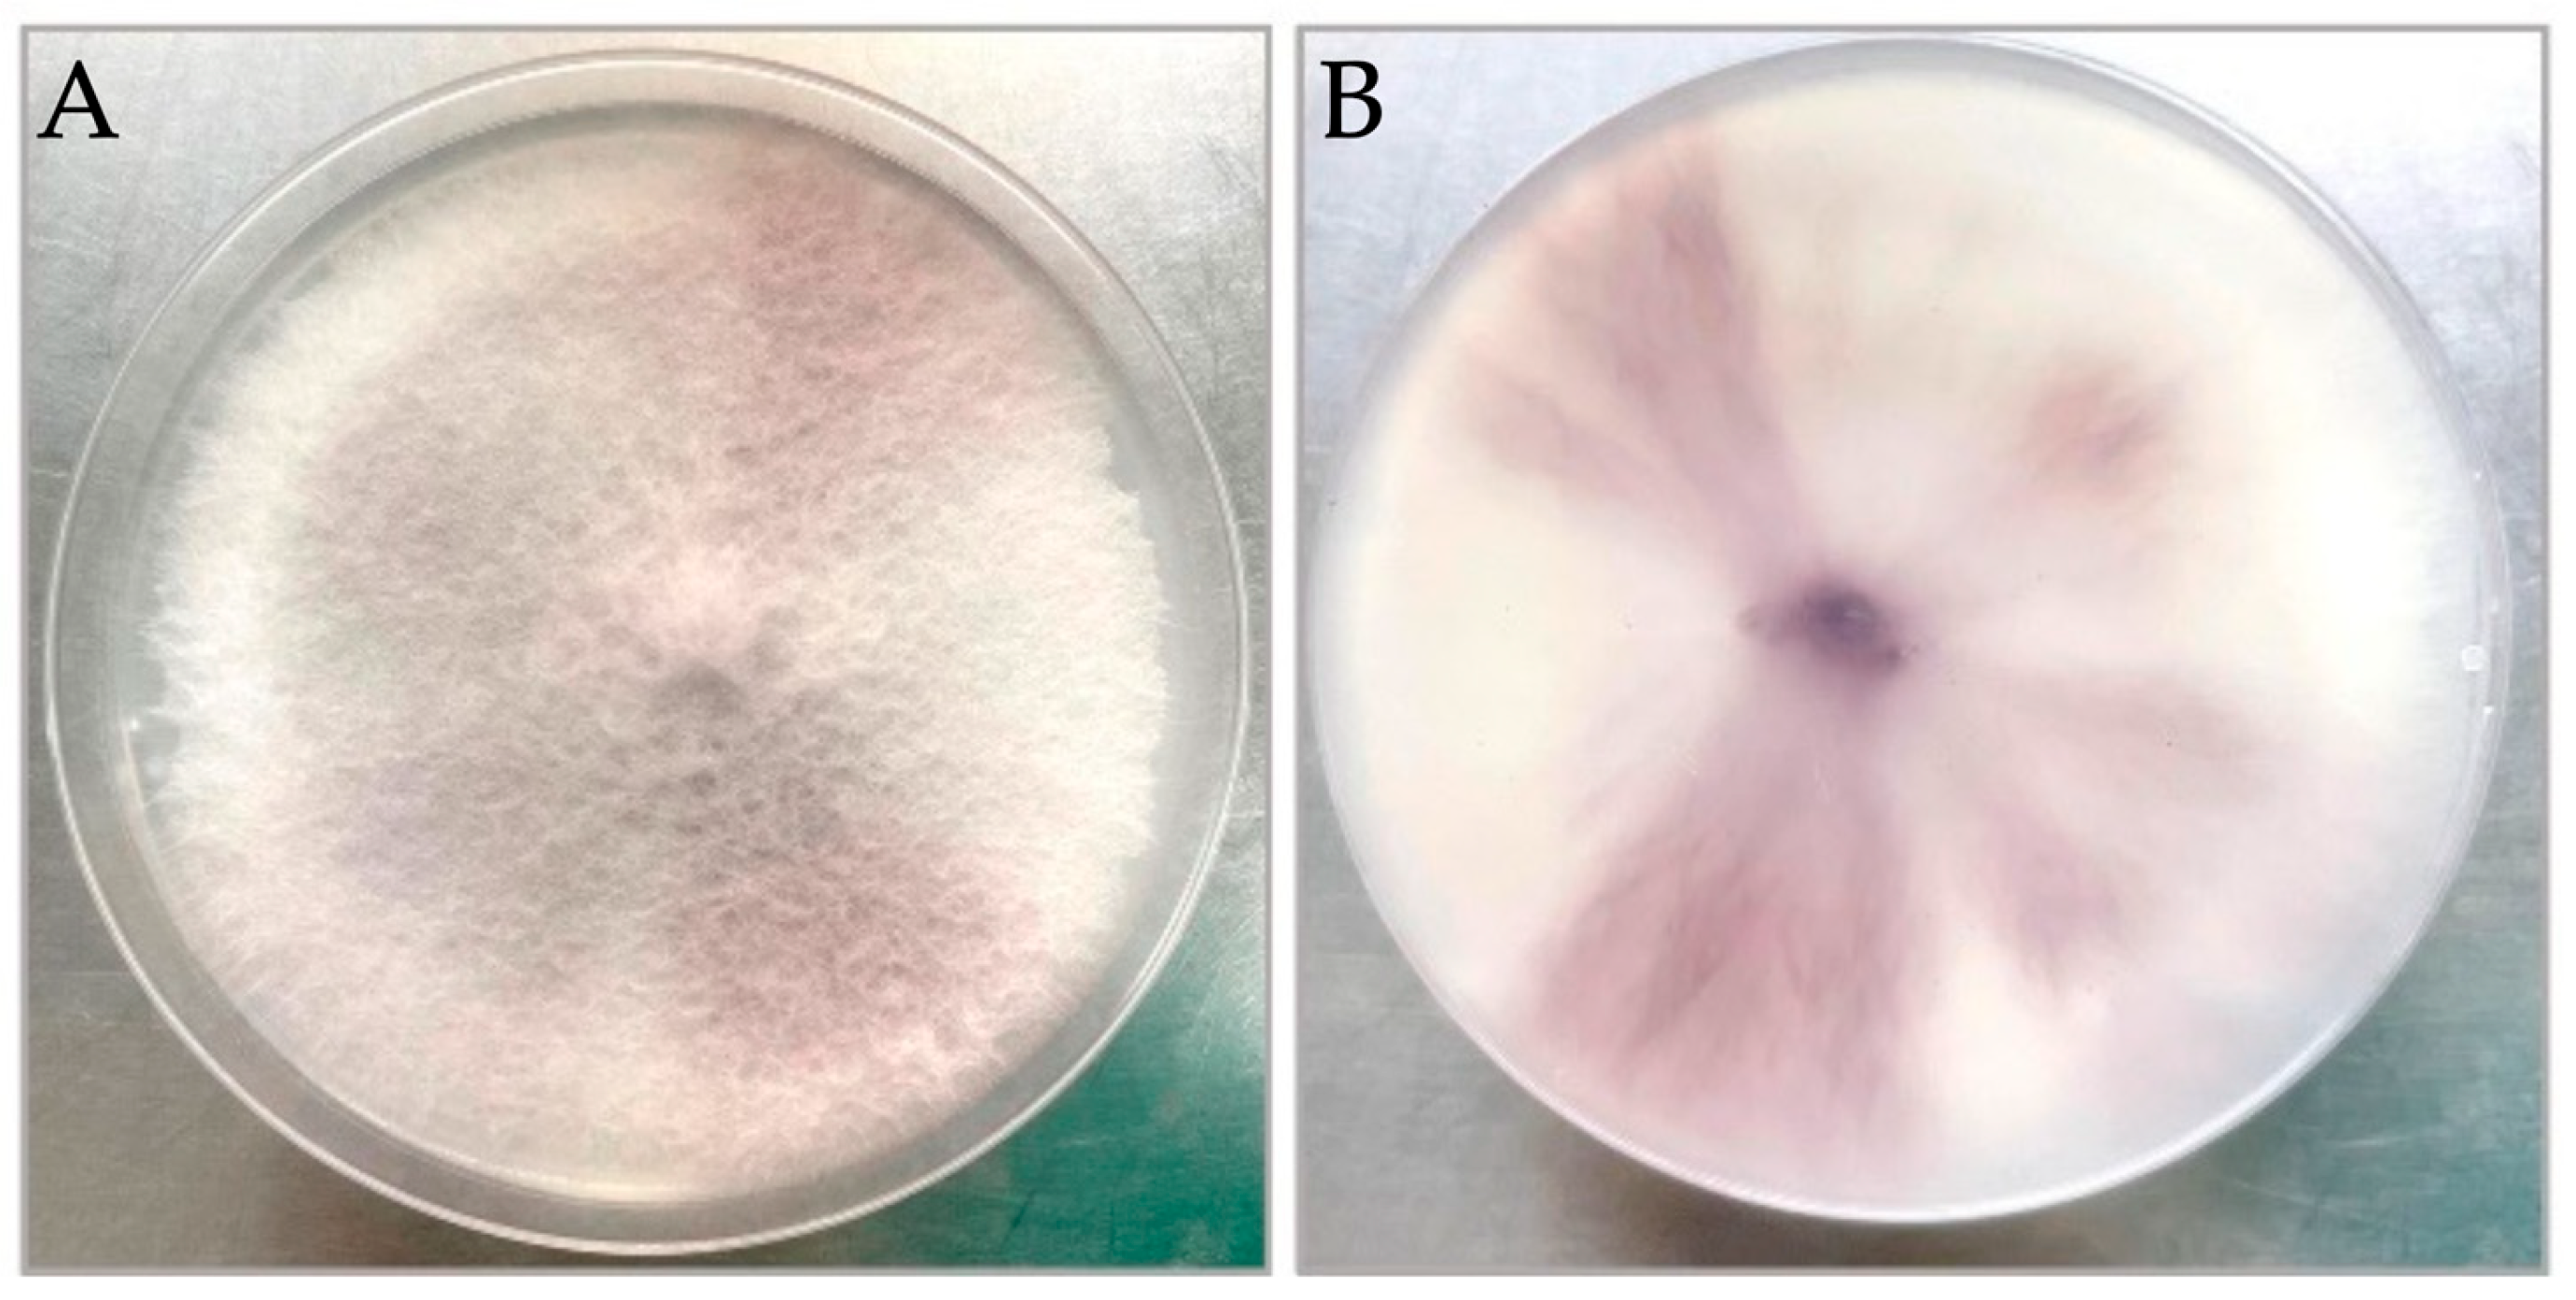
Jof 10 00622 g002

Characterisation of Fusarium oxysporum f. sp. radicis-lycopersici in Infected Tomatoes in Inner Mongolia, China
Abstract
1. Introduction
2. Materials and Methods
2.1. Pathogen Isolation
2.2. Morphological Identification of Pathogens
2.3. Molecular Identification of Pathogen
2.4. Pathogenicity Assay
2.5. Fungicide Sensitivity Assay
2.6. Resistance of Tomato Germplasms
3. Results
3.1. Morphological Identification
3.2. Molecular Identification
3.3. Pathogenicity Test
3.4. Sensitivity of FORL Isolates to Fungicides
3.5. Resistance Screening in Tomatoes
4. Discussion
Supplementary Materials
Author Contributions
Funding
Institutional Review Board Statement
Informed Consent Statement
Data Availability Statement
Acknowledgments
Conflicts of Interest
References
- Benaouali, H.; Hamini-Kadar, N.; Bouras, A.; Benichou, S.L.; Kihal, M.; Henni, J.-E. Isolation, pathogenicity test and physicochemical studies of Fusarium oxysporum f.sp radicis-lycopersici. Adv. Environ. Biol. 2014, 8, 36–49. [Google Scholar]
- Kim, J.T.; Park, I.H.; Hahm, Y.I.; Yu, S.H. Crown and Root Rot of greenhouse tomato caused by Fusarium oxysporum f. sp. radicis-lycopersici in Korea. Plant Pathol. J. 2001, 17, 290–294. [Google Scholar]
- Zhou, M.; Li, B. The current development situation and prospects of tomato seed industry in China. Vegetables 2022, 5, 6–10. [Google Scholar]
- Geng, L.; Li, C.; Chi, S.; Wang, L.; Chai, M. Identification of the pathogen causing Fusarium crown and root rot of tomato and its growth affecting factors. Acta Phytopathol. Sin. 2012, 42, 449–455. [Google Scholar]
- Su, X.; Wang, M.; Lü, H.; Liu, S.; Wang, S.; Hou, L. Identification of the pathogen causing Fusarium crown and root rot and screening resistant varieties in tomato. Shandong Agric. Sci. 2024, 56, 145–150. [Google Scholar]
- Du, J.; Wu, W.; Zhang, X.; Li, Y.; Ding, X. Research progress on the occurrence and control of Fusarium Crown and Root Rot of tomato. Biotechnol. Bull. 2020, 36, 200–206. [Google Scholar]
- Memzies, J.G.; Seywerd, F. Additions to the host rang of Fusarium oxysporum f. sp. radicis-lycopersici. Plant Dis. 1990, 74, 569–572. [Google Scholar] [CrossRef]
- Edel-Hermann, V.; Lecomte, C. Current status of Fusarium oxysporum formae speciales and races. Phytopathology 2019, 109, 512–530. [Google Scholar] [CrossRef]
- Lagopodi, A.L.; Ram, A.F.J.; Lamers, G.E.M.; Punt, P.J. Novel aspects of tomato root colonization and infection by Fusarium oxysporum f. sp. radicis-lycopersici revealed by confocal laser scanning microscopic analysis using the green fluorescent protein as a marker. Mol. Plant-Microbe Interact. 2002, 15, 172–179. [Google Scholar] [CrossRef]
- Liu, L.; Wang, H. Research progress of tomato Fusarium Crown and Root Rot pathogen and resistance breeding. J. Chang. Veg. 2016, 6, 35–37. [Google Scholar]
- Su, X.; Zhu, C.; Liu, S.; Wang, S.; Lü, H. Research progress on tomato Fusarium Crown and Root Rot. Chin. Veg. 2022, 9, 16–21. [Google Scholar]
- Hirano, Y.; Arie, T. PCR-based differentiation of Fusarium oxysporum ff. sp. lycopersici and radicis-lycopersici and races of F. oxysporum f. sp. lycopersici. J. Gen. Plant Pathol. 2006, 72, 273–283. [Google Scholar] [CrossRef]
- Wang, M.; Liu, S.; Hou, L.; Wang, S.; Lü, H.; Su, X. Development of artificial inoculation methodology for evaluation of resistance to Fusarium Crown and Root Rot and screening of resistance sources in tomato. Sci. Agric. Sin. 2022, 55, 707–718. [Google Scholar]
- Fraser, M.; Hwang, S.F.; Ahmed, H.U.; Akhavan, A.; Stammler, G.; Barton, W.; Strelkov, S.E. Sensitivity of Leptosphaeria maculans to pyraclostrobin in Alberta, Canada. Can. J. Plant Sci. 2017, 97, 83–91. [Google Scholar] [CrossRef]
- Yang, Y.; Marcoft, S.J.; Forsyth, L.M.; Zhao, J.; Li, Z.; Van de Wouw, A.P.; Idnurm, A. Sterol demethylation inhibitor fungicide resistance in Leptosphaeria maculans is caused by modifications in the regulatory region of ERG11. Plant Dis. 2020, 104, 1280–1290. [Google Scholar] [CrossRef] [PubMed]
- Li, X.; Li, X.; Qi, Y.; Guo, C.; Li, M. Identification and variety resistance of the pathogen of tomato crown and root rot. J. Gansu Agric. Univ. 2019, 54, 121–127. [Google Scholar]
- McGovern, R.J. Management of tomato diseases caused by Fusarium oxysporum. Crop Prot. 2015, 73, 78–92. [Google Scholar] [CrossRef]
- Cheng, L.; Zhang, S.; Li, Y.; Chen, F.; Cheng, F.; Zhang, X.; Dong, T.; Guo, J. Pathogen identification of Fusarium Crown Root Rot and screening for resistant sources in tomato. Acta Hortic. Sin. 2016, 43, 781–788. [Google Scholar]
- Lievens, B.; Van Baarlen, P.; Verreth, C.; Van Kerckhove, S.; Rep, M.; Thomma, B.P.H.J. Evolutionary relationships between Fusarium oxysporum f. sp. lycopersici and F. oxysporum f. sp. radicis-lycopersici isolates inferred from mating type, elongation factor-1alpha and exopolygalacturonase sequences. Mycol. Res. 2009, 113 Pt 10, 1181–1191. [Google Scholar] [CrossRef]
- Jarvis, W.R.; Shoemaker, R.A. Taxonomic status of Fusarium oxysporum causing foot and root rot of tomato. Phytopathology 1978, 68, 1679. [Google Scholar] [CrossRef]
- Li, J.; Sun, Y.; Zhao, T.; Jiang, J.; Xu, X. Separation identification and biological characteristics of pathogen causing Fusarium crown and root rot of tomato. J. Northeast. Agric. Univ. 2018, 49, 22–30. [Google Scholar]
- Ye, Q.; Wang, R.; Ruan, M.; Yao, Z.; Cheng, Y.; Wan, H.; Li, Z.; Yang, Y.; Zhou, G. Genetic diversity and identification of Wilt and Root Rot pathogens of tomato in China. Plant Dis. 2020, 104, 1715–1724. [Google Scholar] [CrossRef]
- Villarino, M.; De Cal, A.; Melgarejo, P.; Larena, I. Development of a multiplex PCR for the identification of Fusarium solani and F. oxysporum in a single step. J. Plant Dis. Prot. 2021, 128, 1275–1290. [Google Scholar] [CrossRef]
- Ye, Q.; Wang, R.; Ruan, M.; Cheng, Y.; Wan, H.; Li, Z.; Zhou, G.; Yao, Z. Establishment of a KASP-SNP detection method for filamentous fungi Fusarium oxysporum f. sp. lycopersici and Fusarium oxysporum f. sp. radicis-lycopersici. J. Plant Prot. 2022, 49, 879–889. [Google Scholar]
- Lievens, B.; Houterman, P.M.; Rep, M. Effector gene screening allows unambiguous identification of Fusarium oxysporum f. sp. lycopersici races and discrimination from other formae speciales. FEMS Microbiol. Lett. 2009, 300, 201–215. [Google Scholar] [CrossRef]
- El-Aswad, A.F.; Aly, M.I.; Alsahaty, S.A.; Basyony, A.B.A. Efficacy evaluation of some fumigants against Fusarium oxysporum and enhancement of tomato growth as elicitor-induced defense responses. Sci. Rep. 2023, 13, 2479. [Google Scholar] [CrossRef]
- Amini, J.; Sidovich, D.F. The Effects of fungicides on Fusarium oxysporum f. sp. lycopersici associated with Fusarium Wilt of tomato. J. Plant Prot. Res. 2010, 50, 172–178. [Google Scholar] [CrossRef]
- Gayatri, D.N.; Sandhya, D.D.; Lakshmi, S.M.; Laxmi, S.K. Efficacy evaluation of chemical fungicides against Fusarium oxysporum f. sp. lycopersici (FOL). Int. J. Bot. Stud. 2021, 6, 1098–1103. [Google Scholar]
- Ahmad, S.; Anjum, R.; Raza, W.; Ali, Y.; Rehman, M.A. Evaluation of fungicides against Fusarium oxysporum f.sp. lycopersici the cause of Fusarium Wilt of Tomato. J. Plant Environ. 2021, 3, 125–135. [Google Scholar] [CrossRef]
- Kumar, C.K.; Bhat, N.B.; Jagadeeswar, R.; Durga, R.D.; Anitha, K.D. In vitro evaluation of the chemical fungicides against Fusarium oxysporum f. sp. lycopersici causal organism of Fusarium wilt of tomato. Int. J. Chem. Stud. 2021, 9, 401–403. [Google Scholar] [CrossRef]
- Cao, H.; Li, X.; Wang, X.; Bai, H.; Mu, W.; Liu, F. Control efficacy of pyraclostrobin and triazole fungicides against Tomato Crown and Root Rot. Sci. Agric. Sin. 2018, 51, 4064–4075. [Google Scholar]
- Luo, J.; Zhang, D.; Jing, T.; Liu, G.; Cao, H.; Li, B.; Hou, Y.; Liu, F. Pyraclostrobin loaded lignin-modified nanocapsules: Delivery efficiency enhancement in soil improved control efficacy on tomato Fusarium crown and root rot. Chem. Eng. J. 2020, 394, 124854. [Google Scholar] [CrossRef]
- Devran, Z.; Kahveci, E.; Hong, Y.; Studholme, D.J.; Tör, M. Identifying molecular markers suitable for Frl selection in tomato breeding. Theor. Appl. Genet. 2018, 131, 2099–2105. [Google Scholar] [CrossRef] [PubMed]
- Yang, H.; Deng, L.; Feng, C.; Wang, Y.; Yang, Z.; Jiang, J. Mapping analysis of tomato Fusarium Crown and Root Rot resistance gene Frl. North. Hortic. 2024, 2, 1–7. [Google Scholar]
- Sun, Y.; Yang, H.; Li, J. Transcriptome analysis reveals the response mechanism of Frl-mediated resistance to Fusarium oxysporum f. sp. radicis-lycopersici (FORL) infection in tomato. Int. J. Mol. Sci. 2022, 23, 7078. [Google Scholar] [CrossRef] [PubMed]
- Manzo, D.; Ferriello, F.; Puopolo, G.; Zoina, A.; D’Esposito, D.; Tardella, L.; Ferrarini, A.; Ercolano, M.R. Fusarium oxysporum f.sp. radicis-lycopersici induces distinct transcriptome reprogramming in resistant and susceptible isogenic tomato lines. BMC Plant Biol. 2016, 16, 53. [Google Scholar] [CrossRef] [PubMed]
- Yue, Z.; Tian, Z.; Zhang, J.; Zhang, S.; Li, Y.; Wu, Z. Overexpression of lectin receptor-like kinase 1 in tomato confers resistance to Fusarium oxysporum f. sp. radicis-lycopersici. Front. Plant Sci. 2022, 13, 836269. [Google Scholar] [CrossRef] [PubMed]

| Isolate | ITS | TEF-1α | pgx4 |
|---|---|---|---|
| T36-2B1 | OP600555 | OP615672 | OP615676 |
| T36-1f | OP600556 | OP615673 | OP615677 |
| T36-1D | PQ084700 | PQ127019 | PQ127023 |
| T38-1B | PQ084701 | PQ127020 | PQ127024 |
| T38-2C | PQ084702 | PQ127021 | PQ127025 |
| 3-15B1 | PQ084703 | PQ127022 | PQ127026 |
| Scientific Classification of Plant Species | Common Name | Leaf Stage | Isolate * | |
|---|---|---|---|---|
| T36-1f | T36-2B1 | |||
| Solanaceae | ||||
| Solanum melongena L. | Eggplant | 4–5 | * | * |
| Capsicum annuum L. | Chilli pepper | 4–5 | + | + |
| Leguminosae | ||||
| Cicer arietinum L. | Chickpea | 7–8 | * | * |
| Isolate | Fungicide * | EC50 Values/μg·mL−1 |
|---|---|---|
| T36-1f | 97% Hymexazol | 139.308 |
| T38-2C | 275.158 | |
| T36-1f | 97% Tetramethylthiuram disulphide | 15.142 |
| T38-2C | 11.922 | |
| T36-1f | 98% Pyraclostrobin | 1.2982 |
| T38-2C | 0.4681 | |
| T36-1f | 98% Azoxystrobin | 1.520 |
| T38-2C | 1.0980 | |
| T36-1f | 97% Tebuconazole | 0.038 |
| T38-2C | 0.0511 | |
| T36-1f | 98% Prochloraz | 0.005 |
| T38-2C | 0.009 | |
| T36-1f | 98% Thiophanate-methyl | 9.875 |
| T38-2C | 9.490 |
| Germplasm | Disease Index (DI)/% | RT 1 | Germplasm | Disease Index (DI)/% | RT |
|---|---|---|---|---|---|
| Y156 | 62.5 ± 3.5 | HS | B63 | 60.0 ± 7.1 | S |
| Y155 | 57.5 ± 3.5 | S | B64 | 45.0 ± 0.0 | S |
| Y157 | 55.0 ± 0.0 | S | B51 | 45.0 ± 7.1 | S |
| Y530 | 53.1 ± 4.4 | S | B77 | 61.1 ± 5.6 | HS |
| Y61 | 66.9 ± 2.7 | HS | 242 | 72.5 ± 3.5 | HS |
| 151-134 | 27.5 ± 3.5 | MR | 267 | 52.5 ± 10.6 | S |
| 151-14 | 30.1 ± 3.3 | MS | 287 | 65.0 ± 0.0 | HS |
| 151-18 | 47.5 ± 10.6 | S | 311 | 60.0 ± 7.1 | S |
| 62 | 67.5 ± 7.1 | HS | 309 | 67.5 ± 3.5 | HS |
| 207 | 72.5 ± 0.0 | HS | A3 | 61.3 ± 1.8 | HS |
| 216 | 55.0 ± 0.0 | S | 283 | 57.5 ± 3.5 | S |
| 233 | 55.0 ± 7.1 | S | CM 966 | 37.5 ± 3.5 | MS |
| 354 | 60.0 ± 7.1 | S | Caomeifanqie | 35.0 ± 7.1 | MS |
| 351 | 52.5 ± 3.5 | S | Lüluocheng | 45.0 ± 0.0 | S |
| 359 | 61.1 ± 5.6 | HS | Hongniuxin | 37.5 ± 3.5 | MS |
| Neifan 401 | 15.0 ± 3.5 | R | Shengshijinyu | 36.3 ± 1.8 | MS |
| 224 | 47.5 ± 3.5 | S | Huangyuanshuai | 31.3 ± 2.9 | MS |
| B37 | 65.0 ± 7.1 | HS | Shengfen 88 | 33.3 ± 5.9 | MS |
| 229 | 42.5 ± 3.5 | S | Tianmeiyu | 37.5 ± 3.5 | MS |
| 236 | 25.0 ± 0.0 | MR | Hezuo918 | 56.3 ± 2.9 | S |
| B66 | 78.6 ± 0.0 | HS | Shuiguofanqie | 34.8 ± 3.8 | MS |
| B53 | 70.0 ± 0.0 | HS | Caomeifanqie-2 | 40.0 ± 0.0 | MS |
Disclaimer/Publisher’s Note: The statements, opinions and data contained in all publications are solely those of the individual author(s) and contributor(s) and not of MDPI and/or the editor(s). MDPI and/or the editor(s) disclaim responsibility for any injury to people or property resulting from any ideas, methods, instructions or products referred to in the content. |
© 2024 by the authors. Licensee MDPI, Basel, Switzerland. This article is an open access article distributed under the terms and conditions of the Creative Commons Attribution (CC BY) license (https://creativecommons.org/licenses/by/4.0/).
Share and Cite
Yang, Y.; Wang, Y.; Gao, J.; Shi, Z.; Chen, W.; Huangfu, H.; Li, Z.; Liu, Y. Characterisation of Fusarium oxysporum f. sp. radicis-lycopersici in Infected Tomatoes in Inner Mongolia, China. J. Fungi 2024, 10, 622. https://doi.org/10.3390/jof10090622
Yang Y, Wang Y, Gao J, Shi Z, Chen W, Huangfu H, Li Z, Liu Y. Characterisation of Fusarium oxysporum f. sp. radicis-lycopersici in Infected Tomatoes in Inner Mongolia, China. Journal of Fungi. 2024; 10(9):622. https://doi.org/10.3390/jof10090622
Chicago/Turabian StyleYang, Yongqing, Yong Wang, Jing Gao, Zhidan Shi, Wenjin Chen, Haiyan Huangfu, Zhengnan Li, and Yan Liu. 2024. "Characterisation of Fusarium oxysporum f. sp. radicis-lycopersici in Infected Tomatoes in Inner Mongolia, China" Journal of Fungi 10, no. 9: 622. https://doi.org/10.3390/jof10090622
APA StyleYang, Y., Wang, Y., Gao, J., Shi, Z., Chen, W., Huangfu, H., Li, Z., & Liu, Y. (2024). Characterisation of Fusarium oxysporum f. sp. radicis-lycopersici in Infected Tomatoes in Inner Mongolia, China. Journal of Fungi, 10(9), 622. https://doi.org/10.3390/jof10090622









